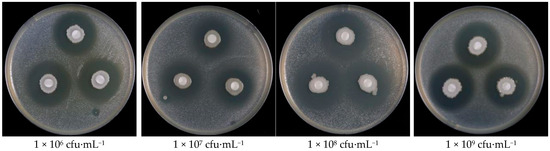

Abstract
Bacterial fruit blotch (BFB) is a devastating disease caused by Acidovorax citrulli, severely impacting the watermelon and melon industries and leading to significant economic losses. Currently, researchers have not identified any commercial melon varieties with high resistance to BFB, and farmers primarily rely on chemical agents for prevention and control. However, the extensive use of these agents contributes to increased drug resistance among pathogenic bacteria, making it essential to develop environmentally friendly control methods. To explore the feasibility of combining the Bacillus velezensis ZY1 strain with chemical agents for BFB management, we assessed the efficacy of 10 bactericides and the ZY1 strain against Acidovorax citrulli. The results show that Prothioconazole, Zhongsheng Tetramycin Solution, Streptomycin Sesquisulfate, Tetramycin, Zhongshengmycin, and ZY1 exhibited significant inhibitory effects on the growth of Acidovorax citrulli. We determined the biocompatibility of the bactericides with the ZY1 strain using the plate confrontation method and the flat counting method. Zhongsheng Tetramycin Solution, Zhongshengmycin, and Kasugamycin exhibited good compatibility with the ZY1 strain. Additionally, we established the optimal compounding ratio of the bactericide and ZY1 using the Horsfall method. Among these, Zhongshengmycin demonstrated the best performance when combining its efficacy against Acidovorax citrulli with its biocompatibility with the ZY1 strain. The combination of Zhongshengmycin and ZY1 at a volume ratio of 5:5 significantly inhibited Acidovorax citrulli, exhibiting a clear synergistic effect with a synergy index (IR) value of 1.542. Field tests conducted over 21 days in Beijing greenhouses, Hainan Field facility greenhouses, and Xinjiang showed that the control efficacy of the Zhongshengmycin and ZY1 combination (89.23%) significantly surpassed that of the single agent Zhongshengmycin (80.35%) and the biocontrol bacterium ZY1 (72.12%). Notably, the application rate of Zhongshengmycin in the mixture was only half that of the single agent, resulting in a significant reduction in chemical usage. The combination of Bacillus velezensis ZY1 and Zhongshengmycin not only decreases chemical usage but also significantly enhances control efficacy compared to using Zhongshengmycin alone.
1. Introduction
Bacterial fruit blotch (BFB), caused by Acidovorax citrulli, is a serious bacterial disease affecting crops worldwide [1]. BFB primarily impacts cucurbit crops and spreads rapidly [2]. Since its discovery in the U.S., BFB has expanded to other regions and countries, currently occurring in nations such as Australia, Brazil, Turkey, Japan, Thailand, Israel, Iran, Hungary, Greece, and in over 10 provinces in China, including Xinjiang, Hainan, Jilin, and Inner Mongolia. This spread has resulted in significant economic losses [2,3]. Currently, no commercially available cultivars exhibit resistance to BFB. The primary strategy for controlling BFB involves the use of chemical agents [4]. However, the long-term excessive use of these chemicals has led to increased resistance among melon crops and has negatively impacted both the environment and public safety [5].
In recent years, biological control has gained increasing attention with the advancement of research in this field [6]. Biocontrol plays a critical role in integrated pest management strategies. The use of biological agents not only reduces reliance on chemical reagents but also avoids leaving harmful residues in the environment. This approach effectively mitigates the environmental impact of chemicals and reduces the risk of phytopathogenic bacteria developing drug resistance [7]. Shi et al. [8] isolated a Bacillus polymyxa G-14 strain from the rhizosphere of melons and conducted greenhouse and field experiments. Their results demonstrated that this bacterial strain significantly inhibited the occurrence and spread of BFB. Furthermore, they found that prophylactic treatment was more effective than curative treatment. Fan et al. [9] showed that Bacillus subtilis 9407 could be used for the biological control of BFB in melons through surfactant-mediated antimicrobial activity and colonization, achieving a biological control efficacy of 61.7%. However, several challenges remain in using single biocontrol agents to manage crop diseases in agricultural production. Diverse environmental conditions and complex soil systems limit the effectiveness of biological control, leading to poor colonization, low survival rates, and unstable biocontrol outcomes [10].
Research into combining biological and chemical agents for disease prevention and control has increased in recent years. This approach compensates for the limitations of biological agents while reducing the need for chemical pesticides [11].
Bacterial biocontrol agents such as Pseudomonas fluorescens, Bacillus subtilis, Bacillus methylotrophicus, and Bacillus megaterium have shown synergistic effects when used in combination with chemical agents to control various diseases, including chili fruit rot and powdery mildew, rice sheath blight, tomato gray mold, tomato root rot, and wheat stripe disease [12,13,14,15,16]. Anand et al. [12] demonstrated that combining Pseudomonas fluorescens (Pf1) with a low concentration of azoxystrobin was highly effective in treating chili fruit rot and powdery mildew. Although Pf1 alone was effective in controlling both diseases, it was less efficacious than using the standard dose of fungicide. Remarkably, combining Pf1 with a 50% reduction in fungicide dosage provided results comparable to using the full dose of fungicide. However, there have been no reports on the combined use of Bacillus subtilis and chemical agents to control BFB in melons. Previously, our laboratory screened and identified a Bacillus velezensis strain ZY1, which exhibits strong antibacterial activity against A. citrulli and shows promising potential for field application [17].
This experiment aims to screen chemical agents compatible with Bacillus velezensis ZY1 and to optimize the compounding ratio of ZY1 and these chemical agents. Additionally, we will conduct field trials in different regions to establish a novel technology for synergistic control of BFB, combining biological agents and chemical bactericides. This study will provide technical support for reducing chemical pesticide usage in melon production.
2. Materials and Methods
2.1. Materials and Bactericides
Melon cultivars: Cucumis melo cv. IVF192 (Beijing greenhouse potted variety), Xizhoumi No. 5 (Hainan field test variety), and Cuibaomi No. 17 (Xinjiang field test variety).
Bacterial strains: Acidovorax citrulli pslb65 (maintained in this laboratory) and Bacillus velezensis ZY1 (maintained in this laboratory).
Bactericides: 10% prothioconazole suspension (Guizhou Daoyuan Biotechnology Co., Ltd., Guizhou, China), 0.3% tetramycin, 1.7% zhongshengmycin soluble liquid (Hailier Pharmaceutical Group Co., Ltd., Qingdao, China), 46% copper hydroxide water-dispersible granules (purchased from Kodiwa Agricultural Science and Technology Co., Ltd., Shanghai, China), 2% zhongshengmycin and 2% kasugamycin wettable powder (Fujian Kaili Biological Products Co., Ltd., Changtai, China), 3% zhongshengmycin wettable powder (Fujian Kaili Biological Products Co., Ltd., Changtai, China), and 4% kasugamycin aqueous solution (Shaanxi Mecro Biotechnology Co., Ltd., Tokyo, Japan), 0.3 Tetramycin aqueous solution (Liaoning Microscience Biotechnology Co., Ltd., Shenyang, China), 72% Streptomycin Sesquisulfate wettable powder (North China Pharmaceutical Hebei Huanuo Co., Ltd., Shijiazhuang, China), 20% Thiobacille Copper Suspension (Zhejiang Longwan Chemical Co., Ltd., Wenzhou, China), 34.5% oxine-copper, 0.5% tetramycin suspension (Qingdao Otis Biotechnology Co., Ltd., Qingdao, China).
2.2. Indoor Toxicity Determination of Test Agents and ZY1 Against pslb65
Toxicity was determined using the plate confrontation method. The pslb65 strain was thawed from −80 °C and cultured on a lysogeny broth (LB: 15 g of tryptone, 10 g of yeast extract, 10 g of NaCl; add 15 g of agar to solid culture medium) plate. After 48–72 h of incubation at 28 °C, single colonies were picked and inoculated into fresh LB medium in centrifuge tubes. The cultures were shaken at 220 rpm and 28 °C for 12–14 h. The concentration of pslb65 was adjusted to approximately 1 × 108 cfu·mL−1 (OD600 = 0.3) using a spectrophotometer (EVOLUTION 300 UV-VIS, Thermo Fisher Scientific, Waltham, MA, USA). The pslb65 strain was then mixed with LB medium at a 1:40 ratio to prepare bacterial plates; the final concentration of pslb65 was 2.5 × 106 cfu·mL−1.
All test bactericides were prepared in sterilized water at their highest, optimal, and lowest concentrations; the concentration of the bactericides was formulated according to the recommended instructions for use, as detailed in Table 1. Sterilized and dried neutral filter paper discs (5 mm in diameter) were placed on the bacterial plates, with three discs per Petri dish. Ten microliters of each drug solution was added dropwise to each filter paper disc, with each concentration gradient repeated in three dishes. Sterilized water served as a blank control. The plates were incubated at 28 °C, and the inhibition zones were observed and photographed after 72 h. The diameter of the inhibition zones was measured using the cross-intersection method, and the inhibition rate was then calculated. The EC50 value was determined, with the experiment repeated three times.

Table 1.
Bactericides concentrations used for testing.
The bacterial inhibition ability of Bacillus velezensis ZY1 suspension was determined using the same method. Bacillus velezensis ZY1 was cultured in LB medium for 24 h, and bacterial suspensions were prepared at concentrations of 1 × 106, 1 × 107, 1 × 108, and 1 × 109 cfu·mL−1. The experiment was repeated three times.
2.3. Determination of Biocompatibility of ZY1 with Chemical Agents
A single colony of the ZY1 strain was selected and inoculated into 5 mL of LB medium, then shaken at 28 °C for 12 h. The concentration of ZY1 was adjusted to approximately 1 × 108 cfu·mL−1 (OD600 = 0.3) using a spectrophotometer. To each 4 mL of LB liquid medium, 500 μL of ZY1 bacterial suspension (1 × 108 cfu·mL−1) and 500 μL of various chemical agents were added. The mixture was incubated at 28 °C with shaking at 220 rpm for 12–14 h. After incubation, the OD value of each bacterial suspension was measured using a spectrophotometer. Simultaneously, 100 μL of the bacterial suspension was evenly spread onto LB plates and incubated at 28 °C for 48 h. The number of bacterial colonies on each plate was recorded. Sterile water, added in equal volume, served as a blank control (CK). Each experiment was repeated three times.
2.4. Laboratory Toxicity Determination of the Compound Against Acidovorax Citrulli
Based on the results from the indoor toxicity assay (Section 2.2) and the biocompatibility assay (Section 2.3), we selected Zhongsheng Tetramycin Solution and Zhongshengmycin for combination with the ZY1 strain. To identify synergistic ratios, a compound toxicity test was conducted using chemical agents and ZY1 at different ratios, following the method described in Section 2.2. The tested chemical-to-ZY1 ratios were 10:0, 9:1, 8:2, 7:3, 6:4, 5:5, 4:6, 3:7, 2:8, 1:9, and 0:10. Inhibition rates and theoretical inhibition rates were calculated using the method described by Cai et al. [18]. Sterile water was used as a negative control. Each treatment was replicated three times. The synergistic effect of combined toxicity was calculated using the Horsfall method [19]. A potentiation ratio (IR > 1) was considered synergistic, IR = 1 was considered additive, and IR < 1 was considered antagonistic.
2.5. Determination of the Efficacy of the Compound Against BFB in Beijing Greenhouse
The experiment was conducted in March 2024 in the glass greenhouse of the Institute of Plant Protection, Chinese Academy of Agricultural Sciences, Beijing. The melon seeds were treated in the trays in which they were rooted. Two-week-old melon seedlings (Cucumis melo cv. IVF192; Zhongcai Seed Industry Technology Co., Ltd., Beijing, China) were sprayed using a spray bottle with A. citrulli pslb65 at a concentration of 1 × 108 cfu·mL−1, with approximately 20 mL of bacterial suspension per seedling.
The treatments were as follows:
① Single dose of Zhongsheng Tetramycin Solution (EC50 = 93.984 mg/L);
② Single dose of Zhongshengmycin (EC50 = 33.427 mg/L);
③ Kasugamycin;
④ Copper Hydroxide;
⑤ Bacillus velezensis ZY1 suspension (1 × 108 cfu·mL−1);
⑥ Compounding agent [VZhongsheng Tetramycin Solution:VZY1 = 6:4];
⑦ Compounding agent [VZhongshengmycin:VZY1] = 5:5;
⑧ Compound preparation [VKasugamycin:VZY1] = 5:5;
⑨ Compounding agent [VCopper Hydroxide:VZY1] = 5:5;
⑩ Sterile water (negative control).
The concentrations of the bactericides were determined based on their effectiveness in controlling the A. citrulli pslb65 strain in the laboratory. Disease severity was assessed on days 7, 14, and 21 post-inoculation. The disease was classified into six grades according to the extent of BFB (Bacterial Fruit Blotch) symptoms [20,21]—Grade 0: no visible symptoms, Grade 1: leaf blotch area < 25%, Grade 3: leaf blotch area 25–50%, Grade 5: leaf blotch area 50–75%, Grade 7: leaf blotch area 75–100%, and Grade 9: complete plant death. The disease index was calculated using the following formula:
Disease index = 100 × ∑ (number of diseased leaves at each level × relative level value)/(total number of leaves surveyed × 9).
Control effect (%) = [(disease value in negative control − disease value in a treatment)/disease value in negative control] × 100.
Each treatment was replicated three times, with 30 melon seedlings per treatment. The experiment was repeated three times.
2.6. Field Trial
In March and July 2024, we conducted field trials in two different regions, Hainan Province and Xinjiang Uyghur Autonomous Region.
2.6.1. Determination of Field Efficacy of Compound Against BFB in Hainan Province
The experiment was conducted from March to April 2024 in a greenhouse facility located in Chaomei Village, Lingshui County, Hainan Province (18.458899° N, 109.957547° E). The melon cultivar used was Xizhoumi No. 5. At the start of the experiment, the early stage of BFB onset was observed. We did not spray additional pathogens. The test site had been used for melon cultivation for several years. The experimental treatments followed the same protocol as described in Section 2.5. Ten-week-old melon seedlings were spray-inoculated using a backpack hand sprayer until run-off (Instrument model: HD-400 Manufacturer: Linon Singapore), with approximately 20 mL of bacterial suspension per plant. The greenhouse was divided into 40 plots, with four replicates per treatment. Each plot measured approximately 15 m2 and contained 40 plants. The bactericide was applied once every 7 days, with three total applications. The types and concentrations of each bactericide were the same as outlined in Section 2.5. After each application, disease severity was assessed using a three-point sampling method, with five plants surveyed per point and all leaves evaluated per plant. The disease index and control effects were calculated as described previously.
2.6.2. Determination of Field Efficacy of Compound Agent Against BFB in Xinjiang
The experiment was conducted in Anning Qu, Urumqi, Xinjiang Uyghur Autonomous Region, from July to August 2024 (43.842563° N, 87.5717991° E). The melon cultivar used was Cuibaomi No. 17. Similar to Section 2.5, the experiment included ten treatments, with three replicates per treatment, and a total of 30 plots, each approximately 22 m2. The experimental protocol and bactericide dosage are identical, as outlined in Section 2.5. Five random points were selected within each plot, with five melon plants surveyed per point. Disease severity was assessed using the same method described in Section 2.6.1.
2.7. Data Statistics and Analysis
In the trial, DPS 8.50 software (Hangzhou Ruifeng Information Technology Co., Ltd., Hangzhou, China) was used to perform one-way analysis of variance (ANOVA), and the LSD method was applied to test significant differences in colony diameter, inhibition rate, colony number, disease index, and control effect.
DPS 8.50 software was used to perform regression equations and median effect concentration (EC50) analysis.
3. Results
3.1. Toxicity Analysis of 10 Chemical Agents and ZY1 Against A. citrulli
Five agents exhibited strong inhibitory effects against the A. citrulli pslb65 strain (Figure 1). The antibacterial rates, from highest to lowest, were as follows: Prothioconazole, Streptomycin Sesquisulfate, Zhongshengmycin, Zhongsheng Tetramycin Solution and Tetramycin. The EC50 values ranged from 17.140 to 321.773 mg·L−1 (Table 2).

Figure 1.
Inhibitory effects of ten chemical agents tested against A. citrulli.

Table 2.
Toxicity of ten chemical agents tested against Acidovorax citrulli.
A: Prothioconazole; B: Zhongsheng Tetramycin Solution; C: Tetramycin Oxine–copper; D: Streptomycin Sesquisulfate; E: Tetramycin; F: Thiodiazole–copper; G: Copper Hydroxide; H: Zhongshengmycin; I: Kasugamycin; J: Zhongshengmycin; K: negative control. The dilution multiples of each chemical agent is located below respective pictures.
The experimental results demonstrated that the biocontrol agent ZY1 significantly inhibited A. citrulli, with the inhibitory effect increasing as the concentration ranged from 1 × 106 to 1 × 109 cfu·mL−1 (Figure 2). The inhibition rates at 1 × 108 and 1 × 109 cfu·mL−1 were significantly higher than those at 1 × 106 and 1 × 107 cfu·mL−1, but no significant difference was observed between 1 × 108 and 1 × 109 cfu·mL−1 (p < 0.05) (Table 3).
Figure 2.
Results of pslb65 inhibition via Bacillus velezensis ZY1.

Table 3.
Toxicity of Bacillus velezensis ZY1 against Acidovorax citrulli.
3.2. Compatibility Analysis of Biocontrol Agent ZY1 Strain with the Tested Agents
The experimental results revealed significant differences in the biocompatibility of various chemical agents with the ZY1 strain (Figure 3 and Table 4). In plates containing Prothioconazole, the ZY1 strain failed to grow. In plates with Tetracycline and Streptomycin Sesquisulfate, the number of ZY1 colonies significantly decreased, indicating inhibition of growth. However, the ZY1 strain grew normally in media containing Zhongsheng Tetramycin Solution, Zhongshengmycin, and Kasugamycin, suggesting good compatibility with these three agents.


Figure 3.
Determination of Bacillus velezensis ZY1 compatibility with tested bactericides.

Table 4.
Effects of the tested bactericides on the growth of Bacillus velezensis ZY1.
A: Prothioconazole; B: Zhongsheng Tetramycin Solution; C: Streptomycin Sesquisulfate; D: Tetramycin; E: Kasugamycin; F: Zhongshengmycin; G: negative control. The dilution of each chemical agent is included below the respective pictures.
3.3. Indoor Toxicity Test of the Combination of Zhongshengmycin, Zhongsheng Tetramycin Solution, and Biocontrol Agent ZY1
Based on the toxicity of the test agents to the pslb65 strain and the compatibility of the biocompatible bacteria, we selected Zhongsheng Tetramycin Solution, Zhongshengmycin, and ZY1 for compounding.
The combined toxicity test results for the combination of Zhongshengmycin and ZY1 (Table 5) indicated that the compound ratios exhibiting synergistic effects were VZhongshengmycin:ZY1 = 2:8, 3:7, 4:6, 5:5, 6:4, 7:3, and 8:2, with actual inhibition rates of 26.91%, 31.23%, 32.22%, 35.31%, 33.70%, 27.90%, and 23.58%, respectively. Among these, the highest synergistic effect and inhibition rate occurred at a volume ratio of 5:5. Therefore, we selected VZhongshengmycin:ZY1 = 5:5 as the optimal compounding ratio.

Table 5.
Co-toxicity of Zhongshengmycin and Bacillus velezensis ZY1 against Acidovorax citrulli.
The combined toxicity test results for the combination of Zhongsheng Tetramycin Solution and ZY1 (Table 6) showed that the compound ratios with synergistic effects were VZhongsheng Tetramycin Solution:ZY1 = 1:9, 2:8, 3:7, 4:6, 5:5, 6:4, 7:3, 8:2, and 9:1. The actual inhibition rates for these ratios were 28.39%, 26.91%, 27.04%, 22.47%, 25.99%, 30.25%, 27.04%, 26.17%, and 25.06%, respectively. Based on the results of the synergistic effect and actual antibacterial rate, we observed a significant synergistic effect at a volume ratio of 6:4, which also yielded the highest actual antibacterial rate. Thus, we concluded that the optimal ratio for compound selection was VZhongsheng Tetramycin Solution:ZY1 = 6:4.

Table 6.
Co-toxicity of Zhongsheng Tetramycin Solution and Bacillus velezensis ZY1 against Acidovorax citrulli.
3.4. Control Effects of Chemical Agents and B. velezensis ZY1 on BFB in Greenhouses
In this study, we evaluated the control effects of four chemical agents and the biocontrol agent ZY1 in a greenhouse setting, as well as the combination of both tools. The compounding ratios for the four combinations were as follows: VZhongshengmycin:ZY1 = 5:5; VZhongsheng Tetramycin Solution:ZY1 = 6:4; VKasugamycin + VZY1 = 5:5; VCopper Hydroxide + VZY1 = 5:5.
As shown in Figure 4 combining three chemical agents (Zhongshengmycin, Zhongsheng Tetramycin Solution, and Kasugamycin) with ZY1 resulted in a higher control effect than single-agent treatments. However, the combination of Copper Hydroxide and ZY1 exhibited a lower control effect than Copper Hydroxide alone. It can be seen from Table S1, the combination of Zhongshengmycin and ZY1 demonstrated the best preventive and therapeutic effects, with disease indices for BFB of 3.45, 8.20, and 9.88 at 7, 14, and 21 days, respectively. The control effects on days 7, 14, and 21 were 87.47%, 79.41%, and 81.92%, respectively, significantly higher than those of the single-agent treatments of Zhongshengmycin and ZY1 (p < 0.05). The synergistic ratio of Streptomycin and ZY1 on day 21 was IR = 1.255. Photographs of the 21-day control effect of different treatment groups on melon can be viewed in Figure S1.

Figure 4.
Control effects of chemical agents and Bacillus velezensis ZY1 on BFB in greenhouses. Note: Disease index and control effects are presented as means ± standard error of at least three independent experiments. Data within each column with different lowercase letters indicate significant differences (p ≤ 0.05).
3.5. Control Effects of Chemical Agents and Bacillus velezensis ZY1 on BFB in the Fields
3.5.1. Field Trial in Hainan Province
The control effects of all four chemical agents combined with ZY1 were higher than those of single-agent treatments with ZY1. The 21-day control effects, ranked from highest to lowest, were Zhongshengmycin + ZY1, Copper Hydroxide + ZY1, Zhongsheng Tetramycin Solution + ZY1, and Kasugamycin + ZY1 (Figure 5). It can be seen from Table S2, the efficacy at days 7, 14, and 21 for Copper Hydroxide + ZY1, Zhongsheng Tetramycin Solution + ZY1, and Kasugamycin + ZY1 did not significantly differ from the single-agent treatments with ZY1. In contrast, the control effects of the combination of Zhongshengmycin and ZY1 at 7, 14, and 21 days were 87.28%, 87.32%, and 90.34%, respectively. These values were significantly higher than those for the single-agent treatments of Zhongshengmycin and ZY1 (p < 0.05). The 21-day synergistic ratio between Zhongshengmycin and ZY1 was IR = 1.049. Photographs of the 21-day control effect of different treatment groups on melon can be viewed in Figure S2.

Figure 5.
Control effects of chemical agents and Bacillus velezensis ZY1 on BFB in the fields of Hainan province. Note: Disease index and control effects are presented as means ± standard error of at least three independent experiments. Data within each column with different lowercase letters indicate significant differences (p ≤ 0.05).
3.5.2. Field Trial in Xinjiang Uygur Autonomous Region
The control effects of the four bactericides combined with ZY1 were superior to those of the single-bactericide and ZY1 treatments. The 21-day control effects, ranked from highest to lowest, were Zhongshengmycin + ZY1, Zhongsheng Tetramycin Solution + ZY1, Copper Hydroxide + ZY1, and Kasugamycin + ZY1. The efficacy at 7, 14, and 21 days for Copper Hydroxide + ZY1 and Kasugamycin + ZY1 did not differ significantly from the single-agent treatments with ZY1. The 7- and 14-day efficacy of Zhongsheng Tetramycin Solution + ZY1 was not significantly different from the single-agent treatments with ZY1, but the 21-day efficacy was significantly higher than that of ZY1 alone (Figure 6). It can be seen from Table S3, the control effects of Zhongshengmycin + ZY1 at 7, 14, and 21 days were 88.99%, 87.96%, and 89.23%, respectively, significantly exceeding those of the single-agent treatments of Zhongshengmycin and ZY1. Additionally, the 21-day synergistic ratio between Zhongshengmycin and ZY1 was IR = 1.170. Photographs of the 21-day control effect of different treatment groups on melon can be viewed in Figure S3.

Figure 6.
Control effects of chemical agents and Bacillus velezensis ZY1 on BFB in the fields of the Xinjiang Uygur Autonomous Region. Note: Disease index and control effects are presented as means ± standard error of at least three independent experiments. Data within each column with different lowercase letters indicate significant differences (p ≤ 0.05).
4. Discussion
BFB can affect crops throughout their entire growth and development, leading to wilting, rotting, and even plant death. This significantly impedes the sustainable development of watermelon and melon industries in various countries [22]. At present, chemical agents are mainly used in the market to control BFB. For example, Dong [23] used Streptomycin Sesquisulfate and No. 1 bactericide to control BFB, and Chen [24] used Copper Hydroxide and agricultural Streptomycin Sesquisulfate to control BFB. However, the excessive use of chemical agents exacerbates issues such as pathogen resistance and pesticide residues in the environment [25]. Biocontrol agents, known for their environmentally friendly properties, have gained increasing attention. Khedher et al. [26] showed that Bacillus subtilis V26 can be a good prevention and control of tuber dry rot on potatoes. However, biological control often acts more slowly and is more susceptible to environmental factors, limiting its widespread use compared to chemical agents [27]. Therefore, combining chemical and biological control offers an advantageous approach. Therefore, we used agents that have been reported and have better effects on the market to control BFB for testing.
As a biocontrol bacteria, the compatibility of B. velezensis with bactericides is the primary reason for their combined use. These synergistic effects demonstrate the potential compatibility between biocontrol microorganisms and chemical fungicides [28,29]. Peng et al. [16] showed that Bacillus subtilis NJ-18 was extremely tolerant to the fungicides Jinggangmycin, Flutolanil, and Difenoconazole. Peng et al. [30] showed that Bacillus subtilis B-001 can grow well in Saisentong. In this study, the growth of ZY1 was unaffected by Zhongshengmycin and Zhongsheng Tetramycin Solution, indicating that ZY1 was tolerant to them. In addition, according to previous results, the suppression of A. citrulli pslb65 infection by B. velezensis ZY1 indicates its role as a microbial biocontrol agent against BFB. Therefore, it is feasible to use B. velezensis ZY1/Zhongshengmycin and Zhongsheng Tetramycin Solution combination to control BFB.
At present, there are more and more reports on the combination of biocontrol agents and bactericides. Liu et al. [31] showed that Bacillus subtilis and Sodium Bicarbonate were used to control ring rot in pears, and the highest inhibition rate of the disease reached 80.91%. Peng et al. [32] showed that the combination of NJ-18 and Jinggangmycin reduced lesion length by 35% and 20%. This shows that combination therapy is more effective than single treatments, which is consistent with the results of our experiments. Field trials conducted in Hainan Province and the Xinjiang Uygur Autonomous Region confirmed that the Zhongshengmycin-ZY1 combination achieved control effects of 90.34% and 89.23%, respectively. These results were significantly higher than the control effects of 86.24% and 80.35% for the single-dose Zhongshengmycin treatments and notably higher than the control effects of ZY1 alone, which were 85.91% and 72.12%, respectively. Therefore, it can be seen that the combination of ZY1 and Zhongshengmycin is a promising approach for the prevention and control of BFB. However, the inhibition zones of ZY1 are higher than that of bactericides, but the control effect of ZY1 in field experiments is lower than that of bactericides. According to our analysis, on the one hand, ZY1 has a very good growth state and the best bacteriostatic state on LB plates. On the other hand, some chemical bactericides have poor dispersibility on LB plates. This may be the cause of this phenomenon.
In disease management strategies, the combination of biocontrol agents and bactericides reduces the dose of bactericides compared with either treatment alone [33]. Arjona-Lopez et al. [34] showed that Fluazinam and rhizobia could effectively control avocado white root rot and reduce the amount of Fuazinam by 10 times. In our trial, the combination of Zhongshengmycin (EC50 = 155.05 mg·L−1) and ZY1 (1 × 108 cfu·mL−1) exhibited the most significant field control effect on A. citrulli when the volume ratio was 5:5, and greenhouse and field controls are the most effective. Compared with the treatment of ZY1 or the bactericides alone, investigation on the efficacy of ZY1 integrated with a reduced dose of bactericides to half of the normal dose effectively reduced the incidence of BFB. Furthermore, the reduced level of bactericide decreased the amount of bactericide residues in food and thereby lowered environmental pollution as well as the risk of bactericide resistance. This can help protect the environment and mitigate the development of drug resistance [32,35]. In addition, under complex environments such as bactericide failure due to resistant strains of pathogen, the combination of biological and chemical control may provide stable disease control [36,37,38]. Previous research has demonstrated that the control of plant disease can be more stable via the combined application of bactericides and Bacillus spp. than either alone [39]. It can be seen that a judicious combination of biological and chemical controls is essential to enhance the advantages while reducing their limitations. In our study, the combination of biological control agent ZY1 with bactericides could reduce the severity of BFB effectively and improve the reliability of disease control compared to the treatment of ZY1 or bactericides alone. Of course, there are still some questions, such as how to explain and prove that ZY1 is active on the leaves in the presence of the bactericides. This needs to be evaluated in our future trials.
Our study indicated that the combination of B. velezensis ZY1 and Zhongshengmycin enhances the efficiency of disease control, which will be a new strategy for controlling BFB.
Supplementary Materials
The following supporting information can be downloaded at https://www.mdpi.com/article/10.3390/agronomy14122797/s1. Table S1: the control effects of chemical agents and Bacillus velezensis ZY1 on BFB in greenhouses. Table S2: the control effects of chemical agents and Bacillus velezensis ZY1 on BFB in the fields of Hainan province. Table S3: the control effects of chemical agents and Bacillus velezensis ZY1 on BFB in the fields of the Xinjiang Uygur Autonomous Region. Figure S1: the results of different treatments of melon in a Beijing greenhouse for 21 days. Figure S2: the results of 21 days of different treatments of melons in Chaomei Village, Lingshui County, Hainan Province. Figure S3: the results of 21 days of different treatments of melons in Anning Qu, Urumqi, Xinjiang Uyghur Autonomous Region.
Author Contributions
Conceptualization, H.W. and Y.Y.; methodology, H.W. and Y.Y.; software, H.W. and Y.Y.; validation, H.W. and Y.Y.; formal analysis, S.H., M.M., T.Z. and W.G.; investigation, H.W., S.H. and Y.Y.; resources, S.H., M.M. and Y.Y.; data curation, H.W. and Y.Y.; writing—original draft preparation, H.W.; writing—review and editing, Y.Y.; visualization, T.Z.; supervision, W.G.; project administration, S.H., M.M. and Y.Y.; funding acquisition, S.H., M.M., T.Z., W.G. and Y.Y. All authors have read and agreed to the published version of the manuscript.
Funding
This work was supported by the Major Science and Technology Special Project of Xinjiang Uygur Autonomous Region (2023A02009), the Hainan Province Science and Technology Special Fund (ZDYF2023XDNY084), the National Key R&D Program of China (2023YFD1401200), and the China Earmarked Fund for Modern Agro-industry Technology Research System (CARS-25).
Data Availability Statement
The original contributions presented in this study are included in the article/Supplementary Material. Further inquiries can be directed to the corresponding author.
Conflicts of Interest
The authors declare no conflict of interest.
References
- Webb, R.E.; Goth, R.W. A seedborae bacterium isolated from Watermelon. Plant Dis. Rep. 1965, 49, 818–821. [Google Scholar]
- Burdman, S.; Walcott, R.O.N. Acidovorax citrulli: Generating basic and applied knowledge to tackle a global threat to the cucurbit industry. Mol. Plant Pathol. 2012, 13, 805–815. [Google Scholar] [CrossRef]
- Ji, W.Q.; Ye, Y.F.; Zhang, A.P.; Yang, Y.W.; Guan, W.; Zhao, T.C. Advances of bacterial fruit blotch in China. China Cucurbits Veg. 2022, 35, 1–8. [Google Scholar]
- Zhao, W.L.; Yang, Y.W.; Wang, T.L.; Jiang, J.; Liu, H.Q.; Zhao, T.C. Sensitivity test and analysis of Acidovorax citrulli to copper sulfate. Plant Prot. 2013, 39, 100–105. [Google Scholar]
- Walcott, R.R.; Fessehaie, A.; Castro, A.C. Differences in pathogenicity between two genetically distinct groups of Acidovorax avenae subsp. citrulli on cucurbit hosts. J. Phytopathol. 2004, 152, 277–285. [Google Scholar] [CrossRef]
- Adhikari, M.; Kim, S.W.; Um, Y.H.; Kim, H.S.; Lee, S.C.; Song, J.Y.; Lee, Y.S. Biological control of bacterial fruit blotch of watermelon pathogen (Acidovorax citrulli) with rhizosphere associated bacteria. Plant Pathol. J. 2017, 33, 170. [Google Scholar] [CrossRef]
- Collinge, D.B.; Jensen, D.F.; Rabiey, M.; Sarrocco, S.; Shaw, M.W.; Shaw, R.H. Biological control of plant diseases—What has been achieved and what is the direction? Plant Pathol. 2022, 71, 1024–1047. [Google Scholar] [CrossRef]
- Shi, Y.; Yang, L.; Wang, X.; Gao, Y.; Liu, W.; Lou, K. Biocontrol of bacterial spot diseases of muskmelon using Paenibacillus polymyxa G-14. Afr. J. Biotechnol. 2012, 11, 16845–16851. [Google Scholar]
- Fan, H.; Zhang, Z.; Li, Y.; Zhang, X.; Duan, Y.; Wang, Q.I. Biocontrol of bacterial fruit blotch by Bacillus subtilis 9407 via surfactin-mediated antibacterial activity and colonization. Front. Microbiol. 2017, 8, 1973. [Google Scholar] [CrossRef]
- Bonaterra, A.; Badosa, E.; Daranas, N.; Francés, J.; Roselló, G.; Montesinos, E. Bacteria as Biological Control Agents of Plant Diseases. Microorganisms 2022, 10, 1759. [Google Scholar] [CrossRef]
- Huang, H.J.; Luo, K. Research progress in the control of plant diseases by the combination of Bacillus and fungicides. Microbiology 2021, 48, 938–947. [Google Scholar]
- Anand, T.; Chandrasekaran, A.; Kuttalam, S.; Senthilraja, G.; Samiyappan, R. Integrated control of fruit rot and powdery mildew of chilli using the biocontrol agent Pseudomonas fluorescens and a chemical fungicide. Biol. Control 2010, 52, 1–7. [Google Scholar] [CrossRef]
- Liu, L.; Liang, M.; Li, L.; Sun, L.; Xu, Y.; Gao, J.; Huang, S. Synergistic effects of the combined application of Bacillus subtilis H158 and strobilurins for rice sheath blight control. Biol. Control 2018, 117, 182–187. [Google Scholar] [CrossRef]
- Ji, X.; Li, J.; Meng, Z.; Zhang, S.; Dong, B.; Qiao, K. Synergistic effect of combined application of a new fungicide fluopimomide with a biocontrol agent Bacillus methylotrophicus TA-1 for management of gray mold in tomato. Plant Dis. 2019, 103, 1991–1997. [Google Scholar] [CrossRef]
- Omar, I.; O’neill, T.M.; Rossall, S. Biological control of Fusarium crown and root rot of tomato with antagonistic bacteria and integrated control when combined with the fungicide carbendazim. Plant Pathol. 2006, 55, 92–99. [Google Scholar] [CrossRef]
- Peng, D.; Li, S.; Chen, C.; Zhou, M. Combined application of Bacillus subtilis NJ-18 with fungicides for control of sharp eyespot of wheat. Biol. Control 2014, 70, 28–34. [Google Scholar] [CrossRef]
- Ji, W.Q.; Yang, Y.W.; Liu, D.H.; Wang, C.L.; Yu, C.Y.; Guan, W.; Zhao, T.C. Complete Genome Sequence of Bacillus velezensis Strain ZY1, a Potential Biological Control Agent for Bacterial Fruit Blotch. PhytoFrontiers™ 2023, 3, 734–737. [Google Scholar] [CrossRef]
- Cai, F.; Yang, C.; Ma, T.; Osei, R.; Jin, M.; Zhang, C.; Wang, Y. An endophytic Paenibacillus polymyxa hg18 and its biocontrol potential against Fusarium oxysporum f. sp. cucumerinum. Biol. Control 2023, 188, 105380. [Google Scholar] [CrossRef]
- Chen, F.L.; Zheng, P.N.; Wang, Y. A trial design about bioassay of insecticide mixed. Pestic. Sci. Adm. 1997, 18, 30–31. [Google Scholar]
- Wang, T.; Guan, W.; Huang, Q.; Yang, Y.; Yan, W.; Sun, B.; Zhao, T. Quorum-sensing contributes to virulence, twitching motility, seed attachment and biofilm formation in the wild type strain Aac-5 of Acidovorax citrulli. Microb. Pathog. 2016, 100, 133–140. [Google Scholar] [CrossRef]
- Ji, W.; Zhao, M.; Fei, N.; Yang, L.; Qiao, P.; Walcott, R.; Zhao, T. Essential Acidovorax citrulli virulence gene hrpE activates host immune response against pathogen. Int. J. Mol. Sci. 2022, 23, 9144. [Google Scholar] [CrossRef] [PubMed]
- Fei, N.Y.; Chen, H.M.; Yang, Y.W.; Guan, W.; Liu, B.Y.; Zhao, T.C. Advances of cucurbit bacterial fruit blotch abroad. China Cucurbits and Vegetables. Chin. Melons Veg. 2022, 35, 1–8. [Google Scholar]
- Dong, C.L.; Yang, Y.W.; Sun, B.X.; Wang, T.L.; Zhe, D.M.; Zhao, T.C.; Gao, J. Effect of chemical treatments on germination of triploid watermelon seeds and control to bacterial fruit blotch. Plant Prot. 2015, 41, 178–184. [Google Scholar]
- Chen, H.Y.; Chen, M.C.; Qin, S.; Xiao, M.; Ji, X.C. Efficiency Test of Fungicides against Bacterial Fruit Blotch of Melon in Hainan Island. J. Change Veg. 2012, 2, 3. [Google Scholar]
- Shin, H.J.; Kim, H.; Beuchat, L.R.; Ryu, J.H. Antimicrobial activities of organic acid vapors against Acidovorax citrulli, Salmonella enterica, Escherichia coli O157: H7, and Listeria monocytogenes on Cucurbitaceae seeds. Food Microbiol. 2020, 92, 103569. [Google Scholar] [CrossRef]
- Khedher, S.B.; Mejdoub-Trabelsi, B.; Tounsi, S. Biological potential of Bacillus subtilis V26 for the control of Fusarium wilt and tuber dry rot on potato caused by Fusarium species and the promotion of plant growth. Biol. Control 2021, 152, 104444. [Google Scholar] [CrossRef]
- Huang, J.; Wei, Z.; Tan, S.; Mei, X.; Yin, S.; Shen, Q.; Xu, Y. The rhizosphere soil of diseased tomato plants as a source for novel microorganisms to control bacterial wilt. Appl. Soil Ecol. 2013, 72, 79–84. [Google Scholar] [CrossRef]
- Jacobsen, B.J.; Zidack, N.K.; Larson, B.J. The role of Bacillus-based biological control agents in integrated pest management systems: Plant diseases. Phytopathology 2004, 94, 1272–1275. [Google Scholar] [CrossRef]
- Thakur, N.; Kaur, S.; Tomar, P.; Thakur, S.; Yadav, A.N. Microbial biopesticides: Current status and advancement for sustainable agriculture and environment. In New and Future Developments in Microbial Biotechnology and Bioengineering; Elsevier: Amsterdam, The Netherlands, 2020; pp. 243–282. [Google Scholar]
- Peng, D.; Luo, K.; Jiang, H.; Deng, Y.; Bai, L.; Zhou, X. Combined use of Bacillus subtilis strain B-001 and bactericide for the control of tomato bacterial wilt. Pest Manag. Sci. 2017, 73, 1253–1257. [Google Scholar] [CrossRef]
- Liu, Y.; Chen, Z.; Liu, Y.; Wang, X.; Luo, C.; Nie, Y.; Wang, K. Enhancing bioefficacy of Bacillus subtilis with sodium bicarbonate for the control of ring rot in pear during storage. Biol. Control 2011, 57, 110–117. [Google Scholar] [CrossRef]
- Peng, D.; Li, S.; Wang, J.; Chen, C.; Zhou, M. Integrated biological and chemical control of rice sheath blight by Bacillus subtilis NJ-18 and jinggangmycin. Pest Manag. Sci. 2014, 70, 258–263. [Google Scholar] [CrossRef] [PubMed]
- Frances, J.; Bonaterra, A.; Badosa, E.; Montesinos, E. Combination of Pseudomonas fluorescens EPS288 and reduced fungicide dose for control of Penicillium rot during postharvest storage of pear. Acta Hortic. 2002, 596, 883–886. [Google Scholar] [CrossRef]
- Arjona-Lopez, J.M.; Tienda, S.; Arjona-Girona, I.; Cazorla, F.M.; Lopez-Herrera, C.J. Combination of low concentrations of fluazinam and antagonistic rhizobacteria to control avocado white root rot. Biol. Control 2019, 136, 103996. [Google Scholar] [CrossRef]
- Kondoh, M.; Hirai, M.; Shoda, M. Integrated biological and chemical control of damping-off caused by Rhizoctonia solani using Bacillus subtilis RB14-C and flutolanil. J. Biosci. Bioeng. 2001, 91, 173–177. [Google Scholar] [CrossRef]
- Brannen, P.M.; Kenney, D.S. Kodiak®—A successful biological-control product for suppression of soil-borne plant pathogens of cotton. J. Ind. Microbiol. Biotechnol. 1997, 19, 169–171. [Google Scholar] [CrossRef]
- Sowndhararajan, K.; Marimuthu, S.; Manian, S. Integrated control of blister blight disease in tea using the biocontrol agent Ochrobactrum anthropi strain BMO-111 with chemical fungicides. J. Appl. Microbiol. 2013, 114, 1491–1499. [Google Scholar] [CrossRef]
- Korsten, L.; De Villiers, E.E.; Wehner, F.C.; Kotzé, J.M. Field sprays of Bacillus subtilis and fungicides for control of preharvest fruit diseases of avocado in South Africa. Plant Dis. 1997, 81, 455–459. [Google Scholar] [CrossRef]
- Zeng, W.; Kirk, W.; Hao, J. Field management of Sclerotinia stem rot of soybean using biological control agents. Biol. Control 2012, 60, 141–147. [Google Scholar] [CrossRef]
Disclaimer/Publisher’s Note: The statements, opinions and data contained in all publications are solely those of the individual author(s) and contributor(s) and not of MDPI and/or the editor(s). MDPI and/or the editor(s) disclaim responsibility for any injury to people or property resulting from any ideas, methods, instructions or products referred to in the content. |
© 2024 by the authors. Licensee MDPI, Basel, Switzerland. This article is an open access article distributed under the terms and conditions of the Creative Commons Attribution (CC BY) license (https://creativecommons.org/licenses/by/4.0/).